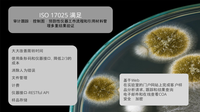
Bika 开源 LIMS 手册第 2 页

Bika 开源 LIMS 项目的主页
|
bika (bi:ka Zulu trad) 报告,从氏族到氏族,带来婚礼、出生、节日和葬礼的消息
|
特点和优势产品
宣传册
Bika用户说Universidad Nacional del Comahue,巴塔哥尼亚 我承认他们在这个产品上所做的出色工作,在开源理念下工作非常舒服,因为这是一种分享和展示工作的方式,我感谢你们每个人的知识、关心和承诺,我祝贺你们作为一个人类和专业团体 - 马科斯-克鲁兹,IAEA研究员,计算机分析员。 Quantum Analytical Services (Pty) Ltd,西开普省 从 2007 年开始使用 BikaBika LIMS 拥有长达十年的 ISO 17025 跟踪记录和支持实验室之间共享的大型在线知识库,我相信它为真正的经济性、开发的专业性和持续的技术支持树立了榜样,我们的同行在内部开发或购买专有LIMS的支出远远超过我们。 它显著地提高了我们实验室的生产力,实现了能源计算自动化、标记超出行业和客户标准的结果,并集成了分析设备、会计和客户输出模块。 我毫不犹豫地推荐 Bika LIMS 作为一种经济高效、设计精良、灵活的产品,用于处理所有实验室(无论大小)的 LIMS 要求,无论所从事的学科如何。 - 实验室负责人 Patrick Griffiths Dr. Akbar Niazi Teaching Hospital,伊斯兰堡 我很幸运我的每一个问题都在 GNU Health、Bika LIMS 和 Orthanc 用户列表上得到了解答,支持简直太棒了 - Khurram Shahzad,软件开发经理 |
中国区域负责人微信号84700802
|